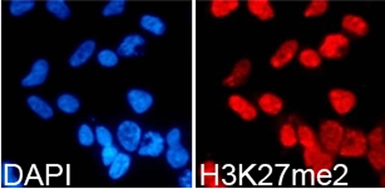

Histone H3K27me2 (di-methyl Lys27) antibody
Cat. No. GTX54105
Cat. No. GTX54105
-
HostRabbit
-
ClonalityPolyclonal
-
IsotypeIgG
-
ApplicationsWB ICC/IF IHC-P Dot ChIP assay
-
ReactivityHuman, Mouse, Rat